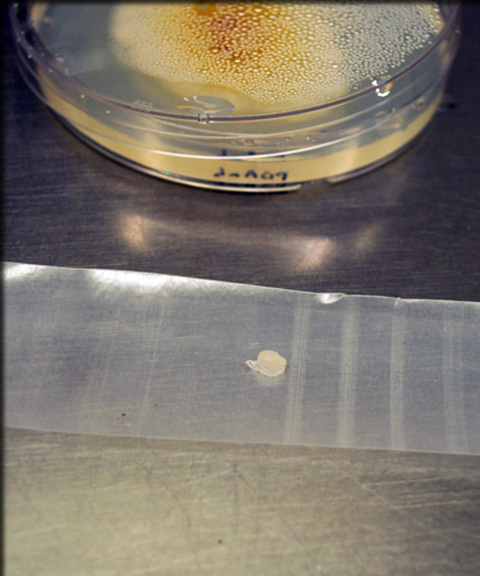

The American Chestnut Project
Research
Tissue Culture and Transformation
Plant tissue culture (micropropagation) is a method of propagating plants asexually
in aseptic conditions. The four main steps of micropropagation are establishment,
multiplication, rooting and acclimatization. An additional step, regeneration, is
needed for embryo tissue culture.
Tissue culture process for American chestnut somatic embryos
The Search for Blight Resistance-enhancing Genes
To enhance blight resistance in the American chestnut tree, we are studying several
gene products, regulatory regions of genes to control expression (promoters), and
the possibility of combining two or more genes (called stacking or pyramiding) for
better and more sustainable resistance.
Search for resistance-enhancing genes
Demo of Blight Resistance
Controlled inoculations of chestnut stems with the blight fungus have confirmed that Darling trees with OxO have consistently smaller cankers than their non-transgenic relatives.
View time-lapse video of a small-stem blight resistance assay demonstrating the high level of blight resistance in two of our new transgenic American chestnut trees.
Small Stem Assay Method
Enhanced Blight Resistance in Transgenic American Chestnut
Enhanced Blight Resistance in Transgenic American Chestnut
Step by Step overview of the small stem assay method.
1. Gather your supplies including an actively growing culture of Cryphonectria parasitica (the blight fungus). In these videos we used strain EP155.
2. Make two marks with a felt pen 5 mm apart.
3. Carefully cut a consistent, vertical wound between the marks.
4. Using a #2 cork borer, cut mycelial plug from the leading edge of the fungal colony.
5. Place mycelial side up on pre stretched parafilm.
6. Press the mycelial plug against the wound making sure it stays in place.

7. Wrap the parafilm tight to prevent drying of the plug and wait 7 to 21 days for results.

